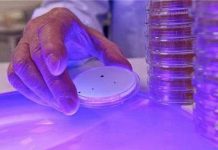
Hệ thống chiếu sáng khử trùng Hệ thống chiếu sáng khử trùng

Trung Quốc muốn xây dựng máy gia tốc hạt CEPC (Circular Electron Positron Collider) với kích thước lớn gấp đôi máy LHC tại Thụy Sĩ nhằm nghiên cứu sâu hơn về hạt Higg Boson – “hạt của Chúa” và có thể là cả vật chất tối, một trong những bí ẩn vật lý lớn nhất thế kỷ 21.
Trung Quốc xây dựng máy gia tốc hạt CEPC lớn gấp đôi máy LHC
Máy gia tốc hạt CEPC có chu vi dự kiến từ 50 đến 100km, lớn hơn rất nhiều so với chu vi hiện tại của máy LHC với 27km. Với kích thước lớn như vậy, nó cũng sẽ tạo ra mức năng lượng lớn gấp 7 lần so với LHC, được cho là giúp các nhà khoa học tạo ra hàng triệu hạt Higg Boson trong 1 lần hoạt động. (Hiện LHC đang hoạt động với mức năng lượng 13 TeV, CEPC được tuyên bố là sẽ hoạt động ở mức 100 TeV, tuy nhiên chưa có nguồn tin cậy để xác minh con số này).
Theo giải thích của Wang Yifang, giám đốc Viện vật lý cao năng lượng thuộc Viện khoa học Trung Quốc thì: “Tính tới nay, LHC chỉ phát hiện được vài trăm hạt Higg boson do nó tạo ra hạt Higg cùng với nhiều hạt khác. Tuy nhiên với CEPC, các vụ va chạm của electron và positron sẽ được tạo ra trong một môi trường cực kỳ sạch nên chỉ sản xuất ra hạt Higg mà thôi. Mặt khác, LHC đã chạm tới giới hạn năng lượng và trông nó cỏ vẻ không thể tăng mức năng lượng một cách đáng kể với cơ sở hạ tầng hiện có”.

Máy gia tốc hạt LHC.
Tuy nhiên, hiện tại thì CEPC của Trung Quốc mới chỉ dừng lại ở mức độ kế hoặc và ý tưởng. Wang cho biết các nhà khoa học đã hoàn thành giai đoạn 1 của thiết kế ý tưởng và đã gởi bảng kế hoạch tới nhiều nhà khoa học quốc tế trong ngành để đánh giá. Bản kế hoạch hoàn chỉnh dự kiến sẽ có mặt vào cuối năm 2016. Giai đoạn đầu trong quá trình xây dựng sẽ bắt đầu vào giữa năm 2020 và 2025, giai đoạn 2 dự kiến triển khai vào năm 2040.
Tuy nhiên, điều mà Wang nói về LHC chỉ có thể đúng ở hiện tại do CERN, tổ chức chịu trách nhiệm vận hành LHC, đã lên kế hoạch nâng cấp LHC lên phiên bản mới mang tên High-Luminosity LHC, mạnh hơn, sáng hơn để tạo ra và quan sát hạt Higg rõ hơn. Kế hoạch dự kiến hoàn tất vào năm 2025 và khi đó, LHC sẽ tạo ra được 15 triệu Higg boson mỗi năm, so với 1,2 triệu hạt tạo ra trong giai đoạn 2011-2012.
| 1 TeV là đơn vị đo năng lượng trong vật lý hạt. 1 TeV bằng khoảng năng lượng chuyển động của một con muỗi đang bay. Điều khiến máy LHC khủng khiếp là nó có thể nén năng lượng vào trong một không gian nhỏ hơn khoảng 1 triệu triệu lần so với kích thước 1 con muỗi.
TeV viết tắt cho chữ tera electron Volts. Nó bằng 1.000.000.000.000 electron Volt hoặc 10^12 electron Volt. 1 eV là đơn vị của năng lượng, sử dụng trong đo lường các quy trình nguyên tử và hạt nhân. Nó là năng lượng trao cho 1 electron bằng cách tăng tốc nó bởi điện thế có độ lớn 1 Volt. |
Theo Tinh Tế